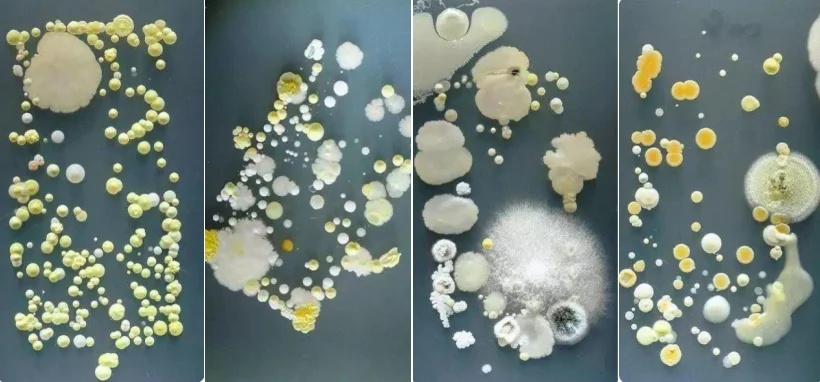

你是不是也这样?
吃饭的时候手机得带上饭桌
睡觉的时候手机放在枕边
甚至蹲马桶的时候
手机也必须得带进厕所……
但是
有一个被你忽略了的大问题——
手机上的细菌
比你想象的多得多!
01
手机上的细菌数
比电梯按钮还多
在你拿起手机之前,是否会特意清洁双手?如果你的答案是“否”,那么请务必留意以下信息!
我们的双手在日常生活中频繁接触各种物品,不经意间就会沾染上细菌、病毒等微生物。一旦这些被污染的手接触到手机,微生物就会随之转移到手机上。

除此之外,在你手机上
那些看不见的细菌
原来数量十分庞大
↓↓↓
一项调研揭示了一个惊人的事实:手机屏幕上的细菌数量,竟然超过了随机抽取的ATM机键盘、马桶冲水按钮以及电梯按钮上的细菌量。

而英国一项关于手机卫生状况的研究更是指出,平均每部手机上的细菌含量,是男厕所冲水手柄的18倍之多。
02
你脸上的痘痘可能跟手机有关
尽管多数手机上的细菌不会立即导致生病,但污染的手机无疑对我们的健康构成了潜在威胁。
特别是那些边玩手机边进食,或是习惯与他人共享手机的行为,更是为疾病的传播提供了可乘之机。

手机上的微生物能通过各种途径如口、鼻、耳等进入人体,宛如一颗隐藏的“健康隐患”。
●这些微生物中,诸如大肠杆菌和金黄色葡萄球菌等常见菌种,极易诱发肠胃问题和呼吸道疾病。
●手机上的数万细菌可能在不经意间通过手指转移到面部,从而可能引发皮肤问题如暗疮,甚至更严重的如肺炎、脑膜炎等健康问题。
●手机屏幕及电池产生的热量,为细菌提供了一个温暖潮湿的生长环境,特别是金黄色葡萄球菌的污染,可导致人体出现丘疹、疖子以及多种严重的疾病。
不同人的手机表面培养出来的菌落
03
听劝!别再带手机上厕所
卫生间是多种病原体滋生的温床,其中包括大肠杆菌、沙门氏菌、霉菌以及诺如病毒等,这些微生物可能导致腹泻、哮喘以及妇科疾病的发生。

在卫生间使用手机时,容易让这些场所内的微生物附着在手机上。随后,这些微生物会通过皮肤接触转移到手上。一旦沾有致病微生物的手触碰到身体其他部位,就可能传播并引发疾病。
所以
上完厕所除了要洗手
还应定期清理手机表面
消灭附着的厕所微生物
当然,最好的做法还是
上厕所不带手机
速战速决
资料丨申工社
编辑丨李玲
*转载请注明来自上海杨浦官方微信

(点击图片查看)



